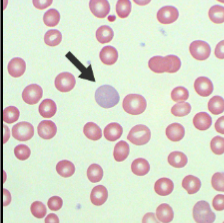
<p>What does this show?</p>
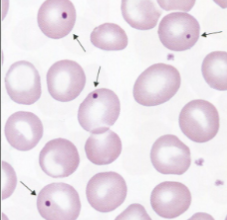
<p>What does this show?</p>
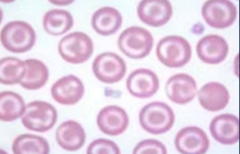
<p>What does this show?</p>
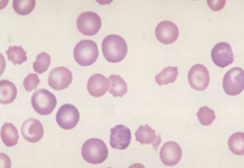
<p>What does this show?</p>
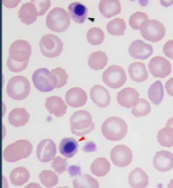
<p>What does this show?</p>
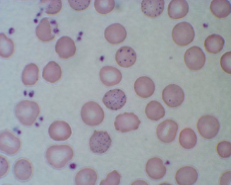
<p>What does this show?</p>
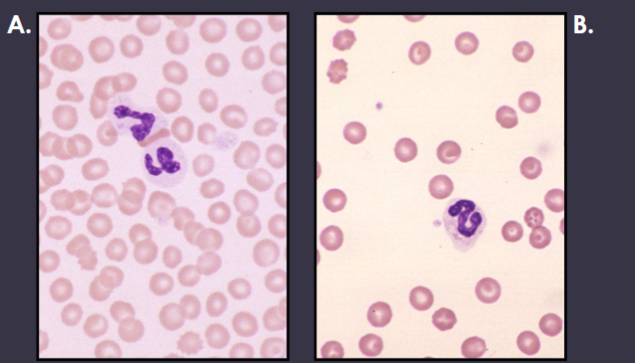
<p>What patient (A or B) would be anemic and why?</p>

1/100
Looks like no tags are added yet.
Name | Mastery | Learn | Test | Matching | Spaced | Call with Kai |
|---|
No analytics yet
Send a link to your students to track their progress
Erythrocyte Evaluation includes
Packed Cell Volume (PCV)
Hematocrit (Hct)
Hemoglobin (Hgb)
Red Blood cell count
PCV -definition
Percentage of whole blood composed of erythrocytes
Used interchangeably with hematocrit
Difference between PCV and HCT
PCV is measures whereas, Hct is Calculated
Potential sources of errors for PCV
Not mixing sample well; invert tube 5-10x
Incorrectly reading results
Centrifuge issues
Inadequate sample to anti-coagulant ratio = inc. amount of anit-coagulant shrinks RBCs causes a false reading
PCV
Accurate estimate of RBC mass
Low cost and rapidly performed in 1-3 minutes
Can be estimated by Hgb x 3
Units = %
For a PCV get used to
Estimating the PCV
Evaluating the buffy coat
Looking at plasma color
EVERY TIME

What is this?
Hematocrit tube
Buffy Coat
Composed of leukocytes, platelets, metarubricytes and reticulocytes
Leukocytosis - buffy coat
Increased/thickened
Leukopenia - Buffy coat
Decreased/small
PCV procedure
Line where the clay sealant and RBCs meet at he 0% on the card reader
Line the top of the plasma at 100% on the card reader
Read PCV where RBCs and buffy coat meet

Buffy coat evaluation
Chromic Lymphocytic Leukemia
WBC - 350,000

Normal Plasma Color
Colorless to pale yellow
Equine plasma color
Typically yellow in color
due to diet from carotene pigments
Icteric Plasma
Dark, more intense yellow color
Cause of Icteric plasma
Increase bilirubin concentration in the plasma
Bilirubin increase due to:
Hemolysis
Liver disease
Bile duct obstruction
Hemolyzed Plasma
Pink or red colored plasma

What is this showing?
Icteric plasma
Causes for Hemolyzed Plasma
Erythrocytes being lysed/rupturing/destroyed/popping
Due to:
improper blood collection
Improper processing techniques
Accelerated intravascular red blood cell destruction

What is this showing?
Hemolyzed plasma
Intravascular hemolysis
RBCs lysing inside the vessel → typically premature lysing
Extravascular Hemolysis
RBCs are lysed and phagocytized by macrophages outside the vessel → can be normal or premature
Cause of Lipemic Plasma
Excess lipid/fat in the plasma
Commonly found in canines and felines
Due to:
Animal recently eating a meal

What is this showing?
Lipemic plasma
Lipemic plasma
Milky white in color
Hematocrit
A value that has been calculated by automated instruments
Hemoglobin
Protein molecule composed of 4 globin chains each bound to a heme group
Oxygen carrying capacity of the erythrocyte
This is the primary job of an erythrocyte
Can be estimated by Hct/3
Units = g/dL
Total Protein
TP or TS (Total solid)
TP - Functions of Plasma
Transporting cells
Transporting Nutrients
Excretion of by products and waste
Maintain homeostasis
Stabilize body temperature and PH
Lipemia and/or hemolysis
Can falsely elevate TP
Materials for a TP
Refractometer
Hematocrit tube
Kim wipes
How to read a Total Protein
Break hematocrit tube where buffy coat and plasma meet
Gently tap side of hand on counter to push plasma out of crti tube and onto the prism then close cover plate
OR
leave cover plate closed and gently tape the crit tube at the top of the refractometer and push plasma out
Read TP where blue and white intersect
Clean prism off with Kim wipe
UNITS = g/dL
What do we NOT do when we go to read a TP?
Tap the prism directly with the crit tube!!!
Primary Proteins
Albumin
Globulin
Albumin
Created in the liver
Keeps fluid inside the vessels
Binds and transports ions and hormones
Provides amino acids to tissues
Globulin
Includes alpha, beta, and gamma globulins
Created in the liver
Gamma globulins (immunoglobulins/IgG) play an important role in the body’s immune defense system
Fibrinogen
Clotting factor
Specific beta globulin
Created in the liver
Marker for increased inflammation
Heat precipitation → used in LA
Clottable (Clauss method) → used in SA
Most common blood tubes used
Red top
Purple Top
Green Top
Blue top
Green top tube
Contains heparin
used for chemistry
Blue top tube
Contains sodium citrate
Purple top tube
Contains EDTA
most commonly used for CBC
RBC indices include
MCV, MCH, MCHC
MCV
Volume (size) of average RBC
Normocytic: normal sized RBCs
Microcytic: RBCs smaller than normal
Macrocytic: RBCs larger than normal
MCV equation
Hematocrit (%) x 10/ RBC count
MCV units
femtoliters (fL)
MCH
Amount/weight of hemoglobin in average RBC
Normochromic: normal amount of Hgb in average RBC
Hypochromic: decreased amount of Hgb in an average RBC
MCV and MCHC
What we focus on when we describe erythrocytes
MCHC
Concentration of hemoglobin in average RBC; how saturated RBCs are with Hgb
Most accurate of the indices becuase RBC count is not used in the calculation
Normochromic: normal conc. of Hgb present in the average RBC
Hypochromic: decreased conc. of Hgb present in the average RBC
MCH equation
Hemogoblin (g/dL) x 10 / RBC count
MCH units
Picograms (pg)
MCHC equation
Hemoglobin(g/dL) x 100 / Hematocrit (%)
MCHC units
grams per deciliter (g/dL)
Hyperchromasia?
DOES NOT EXIST? the limit does not exist
false elevation due to:
lipemia
Hemolysis
incorrect calculation
MCH or MCHC truly above RI?
Use Normochromic to describe

What is the MCV?
73.2fL

What is the MCH?
25.4pg

What is the MCHC?
34.6g/dL

Describe the blood cell picture
Macrocytic and hypochromic

Describe the blood cell picture
Macrocytic and Normochromic
Anemia
Decrease number of erythrocytes in circulation
Causes of anemia
Decrease Production
Increased destruction (hemolysis)
Blood Loss (hemorrhage)
Hgb, Hct, RBC count
Values we look at for aniema
At least 2 have to be decreased to be anemic at the time
If only 1 is decreased, it may be a sign that the patient may be becoming anemic in a couple of days
Regenerative Anemia
Bone marrow is responding to peripheral demand
BM increases RBC production
Release of immature RBCs and into curculation
Look at RBC indices AND RBC morphology
Non-Regenerative Anemia
Inadequate/no bone marrow response to peripheral demand
“The BIG 6” Morphologic Feature of Regeneration
Polychromasia
Anisocytosis; not regeneration specific
Target cells
Howell Jolly bodies
Basophilic stippling
Nucleated Red blood cells/NRBCs
What does this show?
Polychromasia
What does this show?
Howell-Jolly bodies
What does this show?
Target cells
What does this show?
Anisocytosis
What does this show?
NRBC
What does this show?
Basophilic stippling
What patient (A or B) would be anemic and why?
Patient B
You can clearly see that there are significantly fewer red blood cells present in patient B’s blood smear than Patient A’s even though they are both being viewed in the monolayer.
Information used to determine the type of anemia
Microscopic evaluation of the peripheral blood film
Erythrocyte indices
Bone marrow response
Pathophysiologic mechanism
functional changes associated with or resulting from disease or injury
Polychromasia
Macrocytic cell
Immature RBC
Basophilic in color
Large amounts of RNA; given it the blue/purple hue
What is true are polychromatophils and reticulocytes?
ALL polychromatophils are reticulocytes, but not all reticulocytes are polychromatophils
Anisocytosis
General, non-specific term
Change in size of the cell
Can be macrocytic or microcytic
Howell-Jolly bodies
Blue/purple, singular, perfectly round intracellular inclusion
retained piece of nucleus
Nucleated Red blood cell
AKA Metarubricyte
RBC that still has its nucleus
Target cells
“Bullseye target”
Can also be seen in liver disease and increased cholesterol
Basophilic Stippling
Multiple, intracellular, blue/purple dots
Contains dots of RNA
Microscopic evaluation of the peripheral blood film - anemia signs
Increased number of immature cells on film

Describe the blood cell picture and if this patient is anemic.
Macrocytic and Hypochromic
Patient is anemic - RBC count, Hgb, and Hct are all below the RI
Anemia - MCV
Useful in horses (inc. MCV)
don’t release polychromatophils/retics
Macrocytic anemia
usually indicated release of immature cells
Microcytic anemia
Almost always result from iron deficiency
MCHC would be decreased
Normocytic anemia
Usually non-regenerative anemia, OR…
Acute anemia (too soon for marrow response)
Anemia - MCH
Tends to inc. and dec. with size(MCV)
Not as helpful or accurate as MCHC
Anemia - MCHC
Hypochromasia
increase in immature red cells
Iron deficiency anemia
Hyperchromasia?
“the limit does not exist!”
inc. MCHC = Hgb artifact
lipemia, hemolysis, incorrect calculation
Iron Deficiency
Iron is essential for hemoglobin production
Inadequate amount of iron results in hypochromatic erythrocytes
Increased level of central pallor
Causes of Iron deficiency
Inadequate absorption from GI tract
Chronic external blood loss
Iron storages are depleted
Not enough to create new Hgb
external parasites: ticks or fleas
GI bleeds
Questions to ask when determining if regenerative anemia
What should the MCV and MCHC be?
MCV: increased
MCHC: decreased
What should the blood film look like microscopically?
macrocytic
increased number of immature RBCs
3-5 days
The number of days it takes to see an increase in RBCs; the bone marrow needs time to respond to the depletion
7 Days
Peak erythrocyte production
Questions to ask when determining if non-regenerative anemia
Will we see any of “The Big 6”
What should the MCV and MCHC be?
MCV: normocytic
MCHC: Normocromic
What should the blood film look like microscopically
Regenerative Anemia Mechanisms
Blood Loss (Hemorrhage)
RBC Destruction (Hemolysis)
Blood Loss (Hemorrhage)
Ex. HBC
Extravascular loss
Chronic or acute: hemorrhoids or ulcers
Internal: into body cavity or tissues
External: skin, GI, urinary, respiratory tract
RBC Destruction (Hemolysis)
Premature RBC destruction
Immune medicated (body attacking itself)
RBC parasite (microfilaria)
Drugs/chemicals
penicillin, antibiotics, thyroid meds
Often “oxidation” injury
Non-Regenerative Anemia Mechanisms
Defective Erythropoiesis (Internal Marrow Damage)
Immune mediated
Crowding
Decreased Erythropoiesis (external marrow effect)
Defective Erythropoiesis (Internal Marrow Damage)
BM not stimulated to produce new RBCs
Intramedullary; issue with BM
Extramedullary; disease suppressing BM response
Immune Mediated
Intramedullary
Body is attacking its own BM
Crowding
Extramedullary
Neoplastic cells; push out normal RBCs
Think of them as bullies!
Decreased Erythropoiesis (external marrow effect)
Chronic kidney disease (dec erythropoietin)
Inflammatory disease
Basically, chronic inflammtion suppresses erythropoiesis, dec iron availability, dec. erythrocyte lifespan causing anemia
Most common cause of non-reg anemia